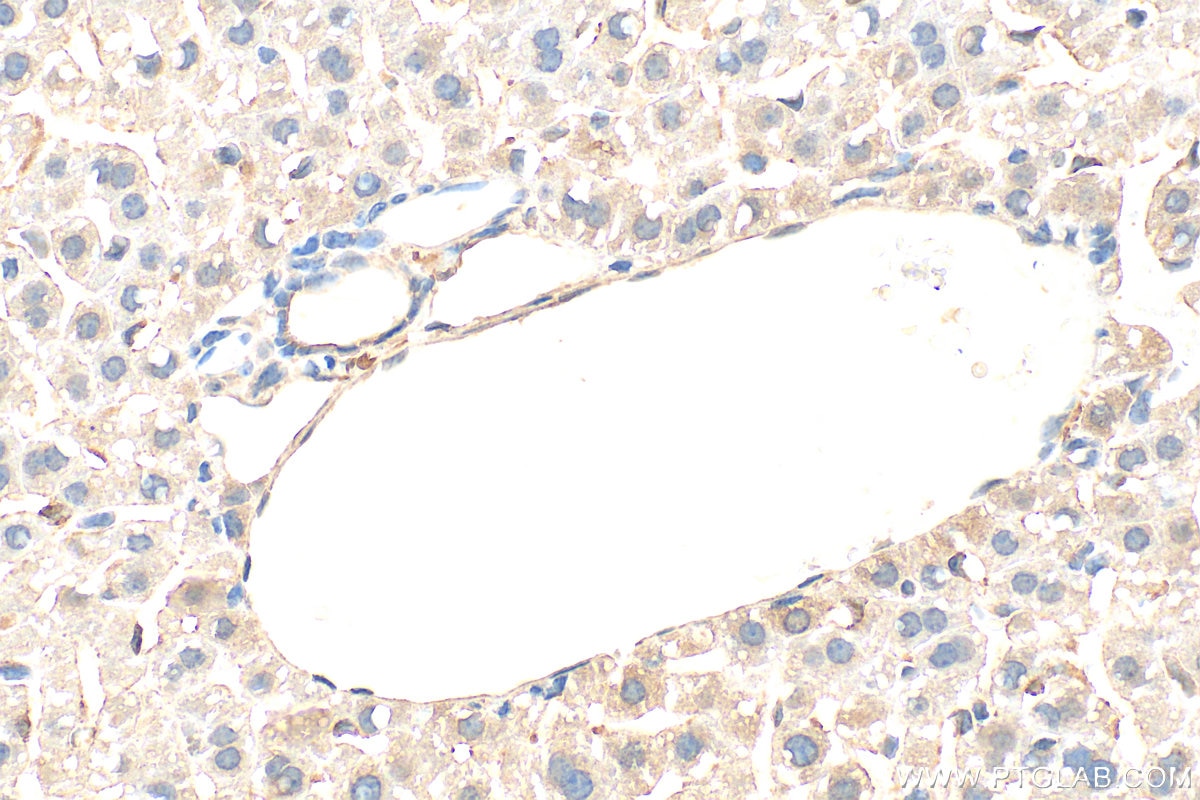
Immunohistochemical analysis of paraffin-embedded mouse liver tissue slide using 60875-5-Ig (Ferritin heavy chain antibody) at dilution of 1:500 (under 40x lens). Heat mediated antigen retrieval with Tris-EDTA buffer (pH 9.0). Immunohistochemistry (IHC) staining of mouse liver tissue using Ferritin heavy chain Monoclonal antibody (60875-5-Ig)

Tested Applications
| Positive WB detected in | A549 cells, K-562 cells, rabbit brain tissue, U-251 cells, HeLa cells, rat brain tissue, rabbit heart tissue, PC-3 cells, HaCaT cells |
| Positive IHC detected in | rat liver tissue, mouse liver tissue Note: suggested antigen retrieval with TE buffer pH 9.0; (*) Alternatively, antigen retrieval may be performed with citrate buffer pH 6.0 |
| Positive IF/ICC detected in | HepG2 cells, HeLa cells |
Recommended dilution
| Application | Dilution |
|---|---|
| Western Blot (WB) | WB : 1:5000-1:50000 |
| Immunohistochemistry (IHC) | IHC : 1:250-1:1000 |
| Immunofluorescence (IF)/ICC | IF/ICC : 1:200-1:800 |
| It is recommended that this reagent should be titrated in each testing system to obtain optimal results. | |
| Sample-dependent, Check data in validation data gallery. | |
Product Information
60875-5-Ig targets Ferritin heavy chain in WB, IHC, IF/ICC, ELISA applications and shows reactivity with human, rat, rabbit samples.
| Tested Reactivity | human, rat, rabbit |
| Host / Isotype | Mouse / IgG2a |
| Class | Monoclonal |
| Type | Antibody |
| Immunogen |
CatNo: Ag21386 Product name: Recombinant human FTH1 protein Source: e coli.-derived, PET28a Tag: 6*His Domain: 1-183 aa of BC000857 Sequence: MTTASTSQVRQNYHQDSEAAINRQINLELYASYVYLSMSYYFDRDDVALKNFAKYFLHQSHEEREHAEKLMKLQNQRGGRIFLQDIKKPDCDDWESGLNAMECALHLEKNVNQSLLELHKLATDKNDPHLCDFIETHYLNEQVKAIKELGDHVTNLRKMGAPESGLAEYLFDKHTLGDSDNES Predict reactive species |
| Full Name | ferritin, heavy polypeptide 1 |
| Calculated Molecular Weight | 183 aa, 21 kDa |
| Observed Molecular Weight | 21 kDa |
| GenBank Accession Number | BC000857 |
| Gene Symbol | FTH1 |
| Gene ID (NCBI) | 2495 |
| Conjugate | Unconjugated |
| Form | Liquid |
| Purification Method | Protein A purification |
| UNIPROT ID | P02794 |
| Storage Buffer | PBS with 0.02% sodium azide and 50% glycerol, pH 7.3. |
| Storage Conditions | Store at -20°C. Stable for one year after shipment. Aliquoting is unnecessary for -20oC storage. 20ul sizes contain 0.1% BSA. |
Background Information
Ferritin heavy chain(FTH1, ferritin, heavy polypeptide 1 ), as a 21 kDa subunit of the ferritin complex, exhibits ferroxidase activity, which serves an essential role in catalyzing the conversion of the ferrous ions (Fe2+) to the ferric form (Fe3+). FTH1 regulates angiogenesis during inflammation and malignancy by binding to high molecular weight kininogen (HKa) and blocking its anti-angiogenic activity on endothelial cells in vitro and in vivo(PMID: 33260500). FTH1 has been shown to protect proximal tube epithelial cells and kidneys against the activity of free iron in reactive oxygen species generation. FTH1 plays an important role in the maintenance of the cellular iron balance in ferroptosis.
Protocols
| Product Specific Protocols | |
|---|---|
| IF protocol for Ferritin heavy chain antibody 60875-5-Ig | Download protocol |
| IHC protocol for Ferritin heavy chain antibody 60875-5-Ig | Download protocol |
| WB protocol for Ferritin heavy chain antibody 60875-5-Ig | Download protocol |
| Standard Protocols | |
|---|---|
| Click here to view our Standard Protocols |
Publications
| Species | Application | Title |
|---|---|---|
Int J Surg Targeting SIRT3 to regulate mitophagy-dependent ferroptosis for preventing glucocorticoid-induced osteoporosis | ||
Int Immunopharmacol Propionate alleviated colitis by modulating iron homeostasis to inhibit ferroptosis and macrophage polarization |